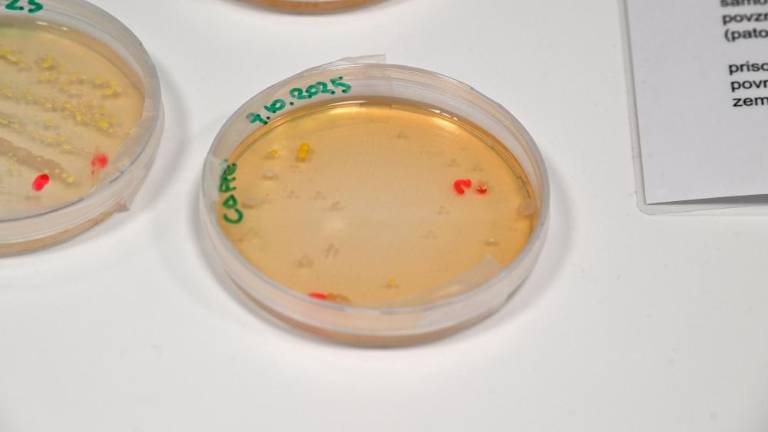
Mladi spoznavali poklice prihodnosti

Prijava

Dark Theme
V znanosti in tehniki se skrivajo poklici prihodnosti, tisti, ki se že nekako kažejo na obzorju, in drugi, za katere si danes težko zamislimo, kakšni bodo. Mladim, ki si želijo znanstvene prihodnosti je bil prejšnji teden med četrtkom in soboto na izobraževalnem zavodu Jožefa Stefana v navdih šolski festival RaSTEM. . Na Canestrinijev trg v Svetoivanskem parku, kjer se zavod nahaja, so prispeli številni ljubitelji znanosti, zlasti otroci in mladostniki, katerim so ponudili predavanja, laboratorijske preizkuse in srečanja ter pravo tržnico znanosti.




